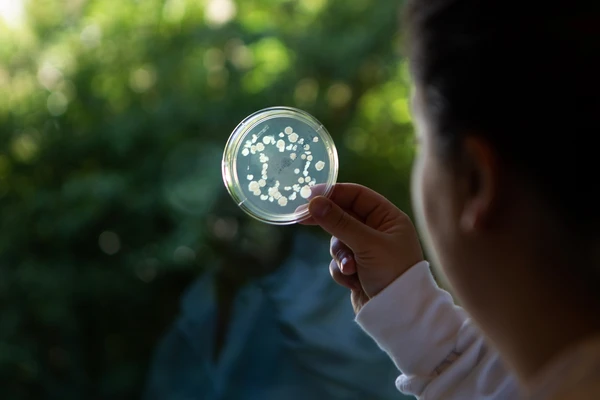
Plants

There's a biosolution for (almost) everything
Delicious cold cuts, healthier guts, thriving crops and so much more. Whatever you need, there's probably a biosolution for it.
Transformative biosolutions for your business and the world
With true collaboration and unparalleled technology we can help transform your business through biology. Benefit from 100+ years of innovation and experience in biosolutions and the top talent in the field. We have deep expertise in 30+ industries so we know your industry. And we have the biotech toolkit and versatility to deliver the exact solutions you need – fast.
Find biosolutions for your industry

Advanced protein solutions
We can help you create tailored protein solutions to meet the exact nutritional needs throughout your consumers’ different stages of life.

Animal
Our unique science-based probiotics, microbes and enzymes work in synergy with your strategies to drive consistent results.

Baking
Treat baked goods with biosolutions designed to deliver healthful, affordable and enjoyable experiences - with your operational flexibility in mind. Combining biology and quality, baking biosolutions help you create exceptional products that delight consumers and support a sustainable future.

Beverages
From non-alcoholic to high-gravity beers, budget to premium wines, and fresh to fermented juices, enzymes and cultures empower you to innovate your process and products.

Biodiesel
Enzymatic biodiesel processing delivers more feedstock flexibility and optimized operating cost.

Biogas
Our extensive biogas portfolio allows you to boost your plant’s profitability with our tailormade solutions, whether your plant processes residues from agriculture, food production, wastewater or sewage.

Biomass
Our blend of enzymes enable you to achieve the right match for your substrates and process conditions, with the lowest cost of production for your biomass conversion.

Carbon capture
Replace chemicals traditionally used for post-combustion carbon capture with biological enzymes to make your carbon capture process more affordable, sustainable and convenient.

Dairy
For thousands of years, pure biology and human innovation have turned change into opportunity in dairy. Now it’s time to take it to the next level.

Dietary supplements
With dietary supplements based on our scientifically researched and clinically tested biosolutions, you can meet people's changing needs at every stage of life.

Dishwashing
From scrubbing power to quick cleaning, our enzymes boost dishwash performance. They also support eco-friendly, biodegradable and renewable formulations.

Distilling
Raise the quality of your spirits, increase efficiency and much more with our distilling enzymes.

Early life nutrition
Imagine every infant getting the best nutritional start. With our biosolutions, your infant formula can provide nourishment closer to how nature intended.

Ethanol
Maximize your starch and fiber-based ethanol and corn oil yields while lowering other inputs and reducing your carbon footprint, with our extensive portfolio of enzymes and yeast.

Fine chemicals
From pharmaceuticals to agrochemicals and cosmetics, fine chemicals are the active ingredients in many products. Manufacturing them responsibly is key to long-term success.

Functional foods
Reimagine food and beverages with high-quality functional food ingredients that help you cater to health-conscious consumers. Fit for food, fit for life.

Home cleaning
Get a more effective, longer-lasting clean and add an extra dimension to your hard surface cleaners with our microbial solutions.

Industrial & Institutional cleaning
Save time and improve efficiencies by letting nature help with cleaning. Partner with us to shape the future of sustainable cleaning!

Laundry
Biology has the power to shape the future of our laundry. With enzymes, you can deliver a superior cleaning experience at a competitive price point that consumers will love.

Leather
As an alternative to chemicals, biosolutions make leather processing gentler and easier - while significantly improving its quality.

Meat
Let’s leverage our biological heritage and shape the future of meat with biosolutions. They help you develop high quality, safe, tasty and sustainable products.

Medical cleaning
Take a closer look at the role enzymes can play in medical detergent.

Oils & fats
Enzymatic processing of oils and fats lets you reduce the use of chemicals, switch to low-cost feedstocks and enjoy better profitability.

Other foods
Get the most out of your cooked meats, seafood, animal coproducts and pet food. Discover how our enzymes and cultures can help you unlock new opportunities.

Pet care
Probiotics, microbial biosolutions and enzymes offer a natural way to create differentiated and innovative pet food, treats and supplements—supporting pet health and well-being, enhancing product palatability, and optimizing production efficiency.
Plant
Our naturally occurring microbes and enzymes help farmers improve plant health and increase crop yield.

Plant-based foods
What if there was just one tool you could use to unlock even more potential for your plant-based food and drinks? Well, there is. We call them: biosolutions.

Pulp & paper
Pulp and paper enzymes are biosolutions that will help your mill keep up with growing demand while meeting your sustainability goals.

Renewable diesel
Meet HVO/HEFA specifications while reducing bleaching clay dosage and oil loss.

Starch
From corn separation to natural sweeteners, our enzymes are central to efficient starch processing.

Sustainable plastics
Enzymatic biosolutions hold the key to reducing the environmental impact of plastics and increasing recyclability.

Textile
Our biodegradable, environmentally friendly enzymes for textiles puts mills and laundries right at the center of the circular fashion movement.
There’s a biosolution for
(almost) everything
Higher crop yields from healthier soil and better animal welfare. Delicious food that stays fresher for longer. Cleaner, softer laundry. Lower emissions and less pollution. Better mental and physical health from birth to old age. These are just some of the many ways our biosolutions transform lives every day.
And we’re just getting started.

All you need to know about biosolutions, delivered monthly
Biosolutions are fascinating but can be difficult to grasp. That's why we created the monthly Biosolutions Bulletin — to break down the science into easy-to-understand, engaging stories with beautiful hand-drawn illustrations.
Each issue dives deep into the science behind biosolutions and their roles in transforming everything from agriculture to industries and the products we use every day.
Sign up today to stay updated!
One more step…
To complete the get in touch form or sign up, please click on the button below to enable cookies.